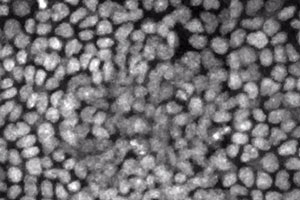

Multimedia

Investigator, Howard Hughes Medical Institute
We have pioneered a new technique for performing long-term, time-lapse videomicroscopy of epidermal growth during embryonic development (see Ouspenskaia et al., Cell, 2016). Using a specially engineered mounting chamber for ex utero embryos, confocal microscopy, and transgenic mice with fluorescent proteins tagged to key subcellular components—in this case histone H2B to label cell nuclei—we can visualize cell divisions and migration in real time, including within the nascent hair follicles, called placodes, and in interfollicular epidermis. The keratinocytes within the placode divide almost exclusively perpendicularly to the underlying basement membrane, giving rise to the stem cells of the hair follicle. In contrast, cells between placodes divide both parallel and perpendicular to the basement membrane.
We engineered a mouse to express fluorescently tagged histone H2B exclusively in the skin epithelium and only in the absence of tetracycline (see Science On-Line Express, Dec 11, 2003). Upon feeding the mice tetracycline, the expression of the transgene is shut off. Cells that divide and give rise to the bulk of the skin epithelium soon dilute out the fluorescent label, leaving only the slow-cycling stem cells labeled (green). These cells are located in the “bulge” of the hair follicle, which is a niche that is just below the sebaceous glands. The skin epithelium is labeled with a red fluorescent dye, incorporated into cellular membranes.
When actin cables are polarized, newly growing microtubules often track along the actin cables for guidance. Essential for establishing cell and tissue polarity, this tracking involves transient tethering of the microtubules to the actin cables, a feature requiring the cytoskeletal crosslinking protein ACF7 (see Kodama et al. Cell 115, 343-354, 2003). Shown is videoimaging depicting actin cables in red (RFP-actin) and the tips of growing microtubules in green (GFP-EB1). WT represents normal mouse endodermal cells; KO represents mouse endodermal cells lacking ACF7.
Through a comprehensive approach encompassing biochemistry, molecular and cell biology, we unveiled a hitherto unrecognized role of ACF7 as an essential molecular goliath that integrates coordinated microtubule and actin dynamics, promotes microtubule targeting to focal adhesions and in turn enhances focal adhesion turnover and cell migration (see Wu et al. Cell 135, 137-148 2008).
In this video, WT and KO keratinocytes were co-transfected with plasmids encoding GFP-EB1 (green, label microtubule plus-ends), DsRed-Zyxin (red, label focal adhesions) and CFP-actin (blue, label F-actin). Cytoskeletal coordination and targeting of microtubules to focal adhesions were then examined by multi-channel confocal spinning-disc videomicroscopy. Images were taken at 1 frame every 3 seconds.
Like epithelial cells, endodermal cells form cell-cell junctions with their neighbors. When wounded, a culture of endodermal cells repairs the injury by polarizing their actin-microtubule cytoskeletons and migrating coordinately into the wound site. In the absence of the cytoskeletal crosslinking protein ACF7, the wound process is perturbed, and cells migrate seemingly irrespective of their neighbors. In the movie, the WT endodermal culture is followed by the KO culture.
In order to serve as effective tracks for cargo transportation in cells, microtubules must be able to transiently attach to the cell periphery. In order to orient transport and movement, microtubules transiently tether to cortical actin patches, which can be dynamically deposited beneath the plasma membrane in response to polarizing cues, such as cell-cell contacts.
ACF7 is a large, cytoskeletal crosslinking protein with actin and microtubule binding domains. When ACF7 is missing, actin-microtubule connections are weakened. In this movie, you can see what happens as a consequence. At the periphery of ACF7 null (KO) endodermal cells, microtubules continue growing and fail to tether/pause at the actin cortex. In wild-type (WT) cells, microtubules normally stop growing and tether/pause at the cell margin, before undergoing “dynamic instability”. The cells for this movie were visualized live, by using GFP-GAS2, a fluorescent fusion protein containing the microtubule binding domain of ACF7 (see Kodama et al. Cell 115, 343-354, 2003).
Here, we transfect ACF7 null (KO) cells with a GFP-ACF7 minigene, a fluorescent fusion protein containing the microtubule and actin binding domains of ACF7. The cells for this movie were visualized live. Note that the microtubules now tether to the actin cytoskeleton, in contrast to the KO cells in the Movie above.
To move naturally within a tissue during development and differentiation, or in response to injury, mammalian cells utilize transmembrane integrin receptors to make and break contacts with their underlying substratum composed of extracellular matrix ligands. On the inside surface of the cell, the cytoplasmic tails of β-integrins form complexes with other proteins and with the actin-myosin cytoskeleton. In the resting state, thick actinomyosin cables anchor to robust integrin-mediated focal contacts, and cells adhere tightly to their substratum. To move, this network must be turned over, a process whose regulation involves the focal adhesion kinase (FAK).
β1 integrin is essential for efficient focal adhesion turnover. Here, we show that when β1 integrin is genetically mutated in epidermal keratinocytes, robust cell surface adhesive contacts form, which are not turned over efficiently. As a consequence, the knockout (KO) cells adhere tightly to the dish, and can’t move effectively. In contrast, wild-type (WT) cells make and break contacts continuously. The actin network is labeled in green with GFP-actin; the integrin-containing focal adhesions are labeled in red with RFP-zyxin. Both the KO and WT cells express β6 integrin, but this integrin needs to work in conjunction with β1 integrin to regulate the focal adhesions.
Segment from Mirsky Lecture 2002.
Movie S2. Assembly and Dynamics of an Integrated Cytoskeleton throughout an Epidermal Sheet
Freshly isolated epidermal keratinocytes were isolated from GFP-actin expressing normal or a-catenin null mice, and plated under conditions to promote cell-cell adhesion. Note that normal keratinocytes use the actin cytoskeletal connections to adherens junctions in order to coordinate movements within a developing sheet of interconnected epithelial cells. In contrast, mice lacking a-catenin (KO) cannot connect the actin cytoskeleton to adherens junctions, and consequently, they don’t form cohesive sheets of epithelial cells. For the complete story, see Vaezi et al. (2002).
Freshly isolated epidermal keratinocytes were isolated from GFP-actin expressing mice, and plated under conditions to promote stratification of the culture. In this series of movie, note that the surface of the epidermal sheet is immobile while the base display intense membrane activity. This difference in actin dynamics correlates with the presence of more linear, mature junctions at the surface of the sheet, and more dotted, immature junctions in midplane optical sections. To learn more about the significance of this difference, see Vaezi et al, (2002).